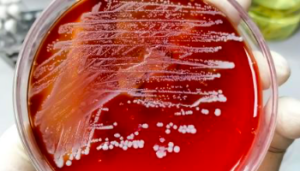

- Office: 813-877-8096
- info@foreonline.org
- Tampa, FL
- Join Our Mailing List
- Course Catalog
FORE_presurgical vaccine_350x200
Foundation for Orthopaedic Research and Education (FORE) > News > News > Could a Presurgical Vaccine Someday Prevent PJIs in Joint Replacement Patients? > FORE_presurgical vaccine_350x200
Copyright © 2026 FORE Online. All rights reserved.
Additional Information
- #11407 (no title)
- 10th Annual ICJR Winter Hip & Knee Course
- 10th Annual ICJR Winter Hip & Knee Course Certificates
- 11th Annual Orthopaedic Trauma & Fracture Care: Pushing the Envelope Presentations
- 12th Annual Current Solutions in Foot and Ankle Surgery
- 14th Annual Trauma 101 Fracture Care For the Community Orthopedist and Orthopaedic PA & NP
- 15th Annual Trauma 101 Fracture Care
- 16th Annual Trauma 101 Presentations
- 2016 Bioskills Symposium Post-Course Page
- 2016 Chicago Sports Med
- 2016 Chicago Sports Med Symposium Certificates
- 2016 Frontiers in Upper Extremity Post Course
- 2016 Frontiers in Upper Extremity Surgery Certificates
- 2016 Orthopaedics for the Primary Care Practitioner & Rehabilitation Therapist Faculty Info
- 2016 Southeastern Fracture Symposium Certificates
- 2016-2017 Publications
- 2017 AAOE Annual Conference
- 2017 AAOE Conference Certificates
- 2017 Baseball Sports Medicine Certificates
- 2017 Baseball Sports Medicine Post Course Page
- 2017 Calusa Ambulatory Spine Conference
- 2017 Calusa Spine Certificates
- 2017 Castellvi Spine Post Course
- 2017 Chicago Sports Post Course
- 2017 CSSE Certificates
- 2017 Current Solutions in Foot & Ankle Surgery Post Course
- 2017 Current Solutions in Orthopaedic Trauma Certificates
- 2017 Current Solutions in Orthopaedic Trauma Post Course
- 2017 Current Solutions in Shoulder & Elbow Surgery Post Course
- 2017 David A. McQueen Memorial Perspectives in Total Joint Arthroplasty: The Hip & Knee
- 2017 David A. McQueen Memorial Perspectives in Total Joint Arthroplasty: The Hip & Knee Certificates
- 2017 David A. McQueen Memorial Perspectives in Total Joint Arthroplasty: The Hip & Knee Certificates
- 2017 Detroit Sports Certificates
- 2017 Detroit Sports Post Course
- 2017 Frontiers in Upper Extremity Surgery Certificates
- 2017 Frontiers in Upper Extremity Surgery Post Course
- 2017 Orthopaedic Research Day
- 2017 Orthopaedic Research Day Certificates
- 2017 Selby Spine Post Course Page
- 2017 Southeastern Fracture Symposium
- 2017 Southeastern Fracture Symposium Certificates
- 2017 Transatlantic Orthopaedic Congress Certificates
- 2017 Transatlantic Orthopaedic Congress Post Course
- 2018 30th Annual Orthopaedic Trauma Update Certificates
- 2018 30th Annual Orthopaedic Trauma Update Post Course
- 2018 3rd Annual Baseball Sports Medicine Post Course
- 2018 6th Annual ICJR South
- 2018 6th Annual ICJR South Certificates
- 2018 7th Annual Direct Anterior Approach Hip Course
- 2018 AAOE Annual Conference
- 2018 AAOE Certificates
- 2018 Atlanta Trauma Symposium Certificates
- 2018 Atlanta Trauma Symposium Post Course
- 2018 Castellvi Spine Certificates
- 2018 Castellvi Spine Post Course
- 2018 Chicago Sports Certificates
- 2018 Chicago Sports Medicine Post Course
- 2018 CSOT Certificates
- 2018 Current Solutions in Foot & Ankle Surgery Certificates
- 2018 Current Solutions in Foot & Ankle Surgery Post Course
- 2018 Current Solutions in Orthopaedic Trauma Post Course
- 2018 Current Solutions in Shoulder & Elbow Surgery Certificates
- 2018 Current Solutions in Shoulder & Elbow Surgery Post Course
- 2018 Frontiers in Upper Extremity Surgery
- 2018 Frontiers in Upper Extremity Surgery Certificates
- 2018 ICJR DAA Certificates
- 2018 ICJR East ISK Certificates
- 2018 ICJR East ISK Hip & Knee Course
- 2018 ICJR Flint Oak
- 2018 ICJR Flint Oak Certificates
- 2018 ICJR Shoulder Certificates
- 2018 ICJR Shoulder Course Post Course
- 2018 Mazama Spine Summit Certificates
- 2018 Mazama Spine Summit Post Course
- 2018 MLB Dominican Republic Sports
- 2018 MLB Winter Meeting Presentations
- 2018 Orthopaedic Research Day
- 2018 Orthopaedic Research Day Certificates
- 2018 Orthopaedic Trauma & Fracture Care
- 2018 Orthopaedic Trauma & Fracture Care Certificates
- 2018 Orthopaedics for the Primary Care Practitioner Post Course
- 2018 Selby Spine Certificates
- 2018 Selby Spine Conference Post Course
- 2018 Southeastern Fracture Symposium Certificates
- 2018 Tampa F&A Reunion Certificates
- 2018 Tampa Foot & Ankle Fellows Reunion
- 2018 Winter SKS Certificates
- 2018 Winter SKS Post Course
- 2019 11th Annual ICJR Revision Hip & Knee Course Certificates
- 2019 11th Annual ICJR Revision Hip & Knee Course Post Course
- 2019 17th Annual Trauma 101 Fracture Care Presentations
- 2019 Atlanta Trauma Symposium Post Course
- 2019 Baseball Winter Meeting – LIVE STREAM
- 2019 Baseball Winter Meeting Presentations
- 2019 Castellvi Spine Certificates
- 2019 Castellvi Spine Symposium Post Course
- 2019 Chicago Cubs Spring Training Seminar Certificates
- 2019 Chicago Cubs Spring Training Seminar Post Course
- 2019 CSFA Certificates
- 2019 CSFA Post Course
- 2019 FORE/AANA World Series of Live Surgery Post Course Page
- 2019 Frontiers in Upper Extremity Presentations
- 2019 ICJR Flint Oak 2019 Post Course
- 2019 ICJR Flint Oak Certificates
- 2019 ICJR Technology Course
- 2019 ICJR Winter Certificates
- 2019 ICJR Winter Hip & Knee Post Course
- 2019 Medical Laboratory Education October 17, 2019 | Auburn, AL Post Course
- 2019 Medical Laboratory Education October 23, 2019 | Florence, AL Post Course
- 2019 MLB London Certificates
- 2019 MLB London Post Course
- 2019 Orioles AT Regional Spine Certificates
- 2019 Orioles AT Regional Spine Course
- 2019 Orioles Athletic Training In-Service Certificates
- 2019 Orioles Athletic Training In-Service Post Course
- 2019 Orthopaedic Trauma & Fracture Care Post
- 2019 SEFS Certificates
- 2019 Selby Spine Certificates
- 2019 Selby Spine Post Course
- 2019 Southeastern Fracture Symposium Post Course
- 2019 Tampa Shoulder Certificates
- 2019 Tampa Shoulder Post Course
- 2019 Winter SKS Certificates
- 2019 Winter SKS Post Course
- 2021 Atlanta Orthopaedic Symposium
- 2021 Castellvi Presentations
- 2021 Detroit Sports Medicine
- 2021 ICJR Flint Oak Certificates
- 2021 Orthopaedic Research Day
- 2021 Othrodpaedics for the Primary Care Practitioner
- 2021 Tampa Shoulder Presentations
- 2021 Winter Baseball Meeting Presentations
- 2022 8th Annual Frontiers in Upper Extremity Surgery
- 2022 Atlanta Orthopaedic Symposium Presentations
- 2022 Castellvi Presentations
- 2022 Current Solution in Foot & Ankle Surgery Presentations
- 2022 ORD Posters Vote Page
- 2022 OrthoVirginia Soccer Medicine Presentations
- 2023 CSFA Videos
- 2023 PBATS Video
- 25th Annual Tampa Shoulder Course Live Surgeries
- 25th Annual Tampa Shoulder Course: Live Broadcasts
- 29th Annual Ortho Trauma Certificates
- 29th Annual Orthopaedic Trauma
- 5th Annual ICJR Shoulder Course
- 5th Annual South/RLO Spring Hip & Knee Course
- 5th South/RLO Spring Hip & Knee Certificates
- 6th Annual 2018 ICJR Revision Hip & Knee Course
- 6th Annual 2018 ICJR Revision Hip & Knee Course Certificates
- 6th Annual Direct Anterior Approach Hip Course Certificates
- 6th Annual Direct Anterior Approach Hip Course Post Course (2017)
- 6th Annual ICJR Shoulder Course
- 6th Annual ICJR Shoulder Course Certificates
- About
- ADC 2016 Certificates
- ADC 2018 Certificates
- ADC Post Course Page
- Affiliated Physicians
- Arthroplasty Disaster 2018 Post Course
- Arthroplasty Disaster Faculty Info
- Athletic Trainer CEUs
- Atlanta Orthopaedic Symposium 2021
- Atlanta Trauma 2017 Post Course
- Atlanta Trauma Symposium Faculty Information
- ATS 2015
- ATS 2016
- ATS 2016 Certificates
- ATS 2017 Certificates
- ATS 2020 Presentations
- Baseball 2018 Certificates
- Baseball Sports Med Certificates
- Baseball Sports Med Post Course Page
- Baseball Sports Medicine: Game Changing Concepts 2020 Presentations
- Board of Directors
- Calusa 2016 Certificates
- Calusa Ambulatory Spine Conference 2016
- Castellvi 2017 Certificates
- Castellvi 2021 LIVE
- Castellvi Spine
- Castellvi Spine 2016 Certificates
- Castellvi Spine Post-Course Page
- Chicago 2015
- Chicago 2015 Certificates
- Chicago 2017 Certificates
- CLICK PLAY ON THE LIVE STREAM BELOW
- Course Catalog
- Course Invite Declines
- Course Support
- CSFA 2016
- CSFA 2016 Certificates
- CSFA 2020 Presentations
- CSOT 2015
- CSOT 2015 Certificates
- CSOT 2016 Certificates
- CSOT 2016 Post Course
- CSOT 2019 Presentations
- CSOT 2020 LIVE from Tampa, FL
- CSSE 2016
- CSSE 2016 Certificates
- CSSE Confirmation
- CSSE Pre-Course
- Current Solutions 2020 Presentations
- Detroit 2018 Certificates
- Detroit Regional Sports Medicine Symposium
- Detroit Sports 2018 Post course
- Detroit Sports 2019 Post Course
- Detroit Sports Med Certificates
- Detroit Sports Medicine Symposium
- Detroit Sports Symposium 2021
- Donations
- Donations-old
- Education
- Educational Partners
- Event Test
- Example Course Title
- Foot and Ankle Conferences 2020
- FORE REGISTRATION SUBMISSION
- FORE/AANA 2019 Live Broadcast Landing Page
- Frontiers 2015 Certificates
- Functional Range Assessment and Functional Range Conditioning – 12/2 – 12/4/2019 Certificates
- Home
- ICJR 5th Annual Revision Certificate
- ICJR 5th Annual Revision Course Post Course
- ICJR 9th Annual Winter Hip & Knee Course
- ICJR Shoulder 2016 Certificates
- ICJR Winter 2017 Certificates
- Live Broadcast of a Reverse Total Shoulder Arthroplasty with an Augmented Baseplate
- Live Broadcast of a Small Reverse Shoulder Arthroplasty
- Live Broadcast of Conversion of a Failed ORIF to Reverse Shoulder Arthroplasty
- LSI SSA Skills Lab 2017
- Mazama 2016 Certificates
- Mazama 2017 Certificate Page
- Mazama Spine 2016
- Mazama Spine 2017 Post Course Page
- MLB 2018 MLB Dominican Republic Sports Certificates
- MLB CME 2020
- MLB Dominican Republic AT Seminar – Nov 3 2019 Certificates
- MLB Winter 2018 Certificates
- MLB WINTER MEETING: ACADEMIC MEETING
- NCOS 2015
- NCOS 2015 Certificates
- News
- NY Baseball 2019 Presentations
- ORD 2016 Certificates
- ORD 2016 Post Course Page
- ORD 2020 Presentations
- Ortho CME
- Orthopaedic CME 2020
- Orthopaedic Conferences
- Orthopaedic Conferences
- Orthopaedic Conferences 2020
- Orthopaedic Research Day 2019
- Orthopaedic Research Day 2019 Live Stream
- Orthopaedic Surgery Conferences
- Orthopaedic Trauma and Fracture Care: Pushing the Envelope
- Orthopaedic Trauma Conferences 2020
- OrthoPCP 2021
- Orthopedic Research Day 2021
- PCP 2016 Certificates
- PCP 2016 Post Course Page
- PCP 2017 Certificates
- PCP 2017 Post Course
- PCP 2018 Certificates
- PCP 2019 Post Course
- Pelvis & Acetabulum Masters Meeting – October 17, 2018
- Pelvis and Acetabulum Masters Meeting
- Pushing the Envelope 2016
- Pushing the Envelope 2016 Certificates
- Pushing the Envelope 2017
- Pushing the Envelope 2017 Certificates
- Pushing the Envelope Faculty Information
- Research
- Research Advisory Board
- Retirement Contributions in Honor of Dr. Kenneth Gustke
- RSS Adult Recon Attendance Tracking
- Scientific Advisory Board
- SDT 2019 Certificates
- SDT 2020 Presentations
- Selby 2016
- Selby 2016 Certificates
- Selby 2020 Presentations
- Selby Best Paper Review Session
- Selby Spine 2017 Certificates
- Selby Spine 2021 LIVE
- Shoulder Conferences 2020
- Social Media Disclaimer
- Staff
- Tampa Foot & Ankle Fellows Reunion
- Tampa Shoulder 2020 Presentations
- Tampa Shoulder Course 2021 LIVE
- Tampa Shoulder Live Demos
- Terms & Conditions
- USF Grand Rounds Stream
- Vegas 2015
- Vegas 2015 Certificates
- Washington State Association of Neurological Surgeons 2016 Annual Meeting
- Winter MLB 2021
- WSANS 2016 Annual Meeting
- WSANS 2017 Certificates
- Appointments
- FAQs
- Contact
- Our Team
- Portfolio